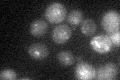
YMR167W
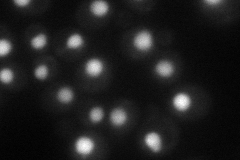
YMR167W
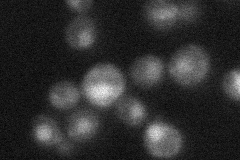
YMR167W

View description
Protein required for mismatch repair in mitosis and meiosis as well as crossing over during meiosis; forms a complex with Pms1p and Msh2p-Msh3p during mismatch repair; human homolog is associated with hereditary non-polyposis colon cancer
Localization:
Intensity:
Fold change:
Significance:
-
C’ GFP library in SD
punctate18.91 -
N' NOP1pr-GFP in SD
nucleus42.2337 -
N' TEF2pr-mCherry in SD

missing0 -
N' NATIVEpr-GFP in SD
punctate,nucleus27.29 -
N' TEF2pr-VC and Cyto-VN in SD

nucleus24.9747 -
C’ GFP library in SD+DTT

punctateN/AN/ANo -
C’ GFP library in SD+H2O2

technical problem0N/ANo -
C’ GFP library in Starvation Media

punctateN/AN/AYes -
C’ GFP library on the background of Pup2-DaMP

punctate -
C’ GFP library on the background of CCT mutant

punctateN/AN/ANo
